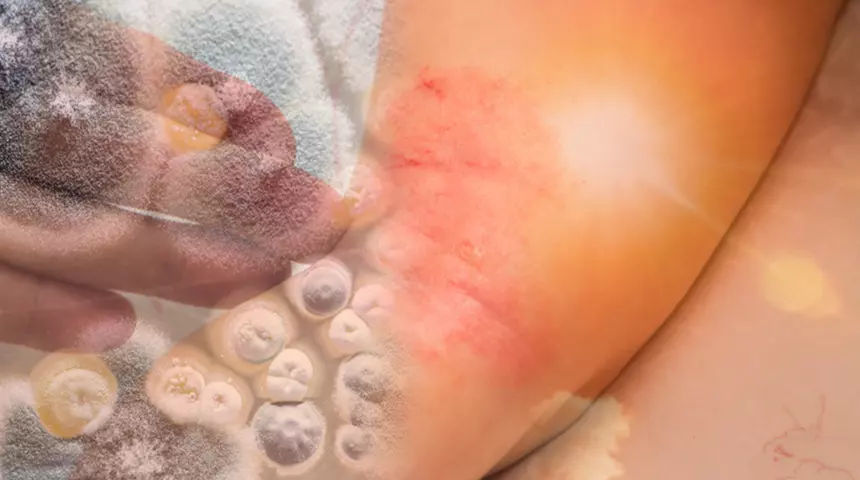

ELAZ.İNFO xəbər verir ki, göbələk infeksiyalarından ehtiyatlı olun! Onlar digər xəstəliklərin xəbərçisi ola bilər.
Yay istiliyinin və rütubətin artması göbələk infeksiyalarının əhəmiyyətli dərəcədə artmasına səbəb olur. Yay aylarında göbələk infeksiyalarının əhəmiyyətli dərəcədə artdığını qeyd edə bilərik. İsti hava, tərləmə, uzun müddət ayaqları bağlı ayaqqabı geyinmək, üzgüçülük və ya üzgüçülükdən sonra dərinin yaxşıca qurudulmaması kimi faktorlar göbələklərin böyüməsi üçün ideal mühit yarada bilir.
Adilə VƏLİYEVA Pediator